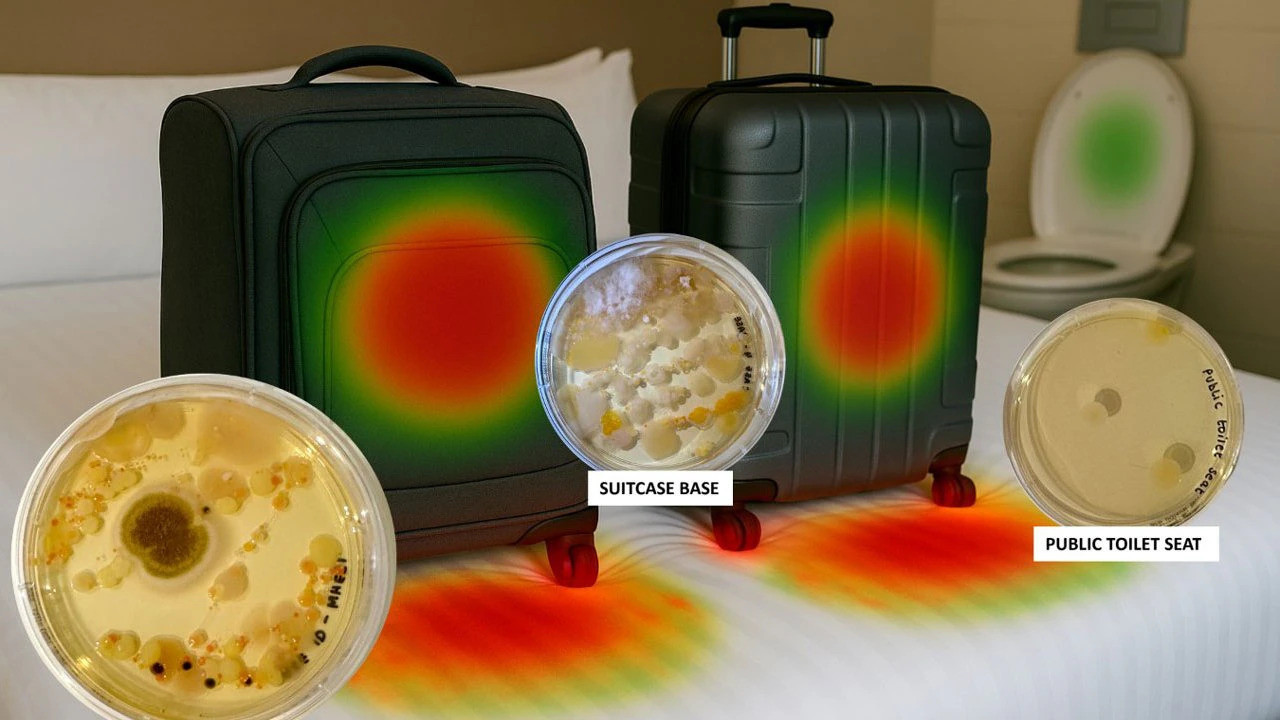
42 ytgrwqv3fsab.jpg

Trong một nghiên cứu do công ty bảo hiểm du lịch InsureandGo thực hiện trong tháng 6 mới đây, các nhà khoa học đã lấy mẫu bánh xe, đáy và tay cầm của vali du lịch để xét nghiệm vi khuẩn.
![]() |
![]() |
"Kết quả cho thấy bánh xe và phần mặt đáy của vali du khách dùng mỗi khi đi du lịch có thể mang theo lượng vi khuẩn cao gấp 58 lần so với bệ ngồi toilet công cộng", Amy-May Pointe, chuyên gia vi sinh vật, khẳng định trên Daily Mail.
Theo đó, nguyên nhân bắt nguồn từ việc bánh xe và phần mặt đáy vali là nơi tiếp xúc trực tiếp với các bề mặt sàn, đường phố,... trong suốt hành trình di chuyển.
Để giữ vali sạch sẽ, các chuyên gia khuyến nghị du khách nên đặt vali lên giá đỡ hành lý trong khách sạn thay vì để dưới sàn hoặc trên giường.
"Nếu phòng khách sạn không có giá để đồ, du khách có thể dùng mũ tắm bằng nilông bọc bánh xe để ngăn vi khuẩn lây lan lên thảm, giường", Amy-May Pointe nhấn mạnh.
Nếu có thể, du khách nên để ý để tránh tránh kéo vali qua những vũng nước hoặc khu vực bẩn, chưa được vệ sinh trên đường tới sân bay. Càng ít tiếp xúc với bùn đất, vali càng sạch.
Ngoài ra, để đảm bảo vệ sinh, du khách nên rửa tay sau khi kéo và sử dụng vali. Bởi tay nắm là nơi dễ nhiễm khuẩn hoặc bị bẩn trong suốt chuyến đi.
"Rửa tay sau mỗi lần kéo vali là điều cần thiết. Hãy coi như tay bạn vừa chạm vào bồn cầu. Và các nghiên cứu đã chứng minh điều này là thật", nữ chuyên gia khẳng định.
Ngay khi về đến nhà, du khách nên lau vali bằng khăn tẩm dung dịch khử khuẩn, nước xà phòng.
Trong trường hợp bánh xe vali có thể tháo rời, du khách cũng nên ngâm chúng trong nước ấm pha xà phòng. Vỏ vali có thể lau sạch bằng thuốc tẩy nhẹ nếu là vỏ nhựa cứng.
Nếu vali làm bằng vải, hãy hút bụi hoặc chà sạch bằng baking soda để loại bỏ nấm mốc.
Theo VietNamnet

